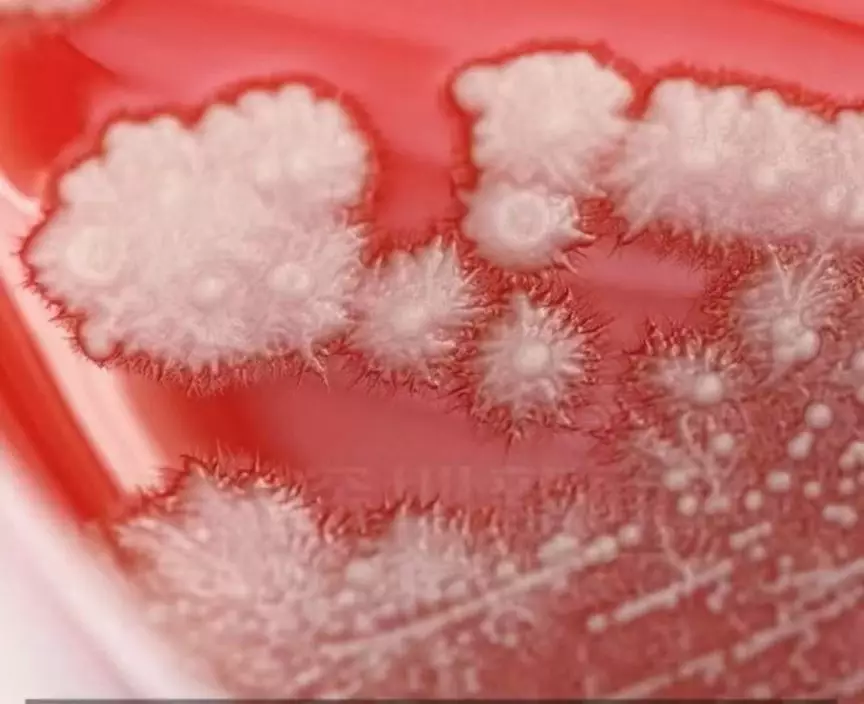

浙江一名男子一感冒就自行服用抗生素消炎止痛,喉嚨竟「長出雪花」,就醫確診真菌性咽喉炎。

男子感冒服用抗生素消炎止痛喉嚨「長出雪花」,就醫確診真菌性咽喉炎。資料圖片
男子長期亂服抗生素反致病情惡化
綜合內媒報導,浙江寧波一名36歲張姓男子從事銷售工作,長期需要熬夜出差,導致生活作息極其不規律。每當出現喉嚨痛及頭痛等感冒症狀時,張男便自行前往藥房購買含抗生素的阿奇黴素服用,以為能「消炎止痛」。豈料,近日張男的病情一個月過後不但未見好轉,喉嚨反而愈發腫痛,遂前往寧波北侖區第二人民醫院求診。

男子感冒服用抗生素消炎止痛喉嚨「長出雪花」,就醫確診真菌性咽喉炎。資料圖片
喉嚨長出「雪花」 男子確診真菌性咽喉炎
醫生檢查發現,張男的咽喉黏膜上覆蓋一層白色絨狀斑塊,外觀宛如「雪花」般,最終確診為「真菌性咽喉炎」。醫生指出,抗生素雖然可以殺滅致病菌,但同時也會破壞人體內的正常菌群,導致「白色念珠菌」迅速滋生。加上患者作息不規律、壓力過大且免疫力下降,更容易讓真菌趁虛而入,引發真菌性咽喉炎。
男子感冒服用抗生素消炎止痛喉嚨「長出雪花」,就醫確診真菌性咽喉炎。網上圖片
濫用抗生素恐生「超級細菌」
專家警告,抗生素主要用於治療細菌感染,若濫用不當不僅無助於康復,更可能破壞腸道菌群,引起腹瀉、皮疹等副作用,長期濫用甚至會使體內產生抗藥性,增加感染「超級細菌」風險。專家提醒,抗生素並不等於消炎藥,出現喉嚨痛或發燒等症狀時,應及時求醫,切勿自行購藥。

男子感冒服用抗生素消炎止痛喉嚨「長出雪花」,就醫確診真菌性咽喉炎。網上圖片
服藥應遵醫囑 勿自行停藥或調整劑量
內地醫療機構提醒,抗生素的使用必須遵從醫生指示,切勿自行停藥或調整劑量。國家藥監局指出,不少患者在症狀好轉後擅自停用抗菌藥物,導致病情反覆並增加耐藥風險,央視健康頻道則強調,抗菌藥物須足夠療程使用,才能確保感染徹底清除。醫生建議,患者應如實告知病史與過敏情況,並在服藥期間密切觀察身體反應,如出現異常應及時就醫。













